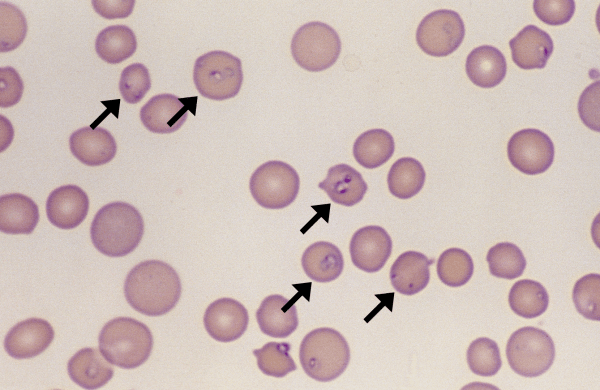

Morphology: elongated organism with undulating membrane, dark nucleus located centrally, small round purple dot (kinetoplast) located at anterior end, and flagellum extending from posterior end. Usually seen in a curved C… Read more Trypanosomes →

Morphology: long worm-like organism in the background of peripheral blood smear. Look alike: trypanosomes, other filarial organisms such as equine onchocerciasis (Onchocerca cervicalis) and canine heartworm (Dirofilaria immitis) Clinical relevance: Setaria equina is… Read more Setaria equina →

Morphology: intracellular yeast-like organisms with a pseudocapsule in the cytoplasm of neutrophils and monocytes. May be 1 – 20 organisms per cell. Organisms may be present in > 25% of… Read more Histoplasma →

Morphology: small ring-shaped piroplasms with a dark eccentric nucleus inside red blood cells. Usually 1 – 2 piroplasms per red cell. Look alikes: siderocytes, Howell-jolly bodies, Babesia felis Commonly seen with: Mycoplasma haemofelis (concurrent… Read more Cytauxzoon felis →

Morphology: single or multiple pear-shaped (pyriform) organisms within red blood cells. Organisms stain dark purple around the periphery and clear in the centre. Look alike: Histoplasma capsulatum Commonly seen with: other tick-borne rickettsial… Read more Babesia →

Morphology: small, round, dark purple inclusions located at the periphery of red cells. Usually 1 – 2 bacteria per red cell. Present in up to 90% of red cells. Look alike: Howell-Jolly… Read more Anaplasma marginale →